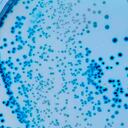

Los casos de coronavirus en el mundo continúan dejando su estela de muerte en varios países y, hasta el momento, la cifra de fallecidos en el mundo llega a 1.989.835 y 92.903.924 infectados. Aunque cerca de 40 países ya empezaron a vacunar a su población, aún es incierto cuánto durará el virus entre la población y muchas personas a quienes ya les dio la covid-19 se aferran a una inmunidad.

A propósito, un estudio liderado por la agencia Public Health England, que depende del Ministerio de Sanidad del Reino Unido y asesora sobre la salud de la población, estableció que las personas que han superado el coronavirus tienen un promedio del 83 % de inmunidad frente a la enfermedad durante al menos cinco meses, no sin antes aclarar que pueden volver a contraer y transmitir el virus.
Para llegar a esa conclusión, los científicos reclutaron a cerca de 21.000 sanitarios de hospitales británicos, quienes fueron divididos en grupos, dependiendo si habían pasado la infección o nunca se contagiaron. Posteriormente, entre los meses de junio y noviembre de 2020 fueron sometidos a pruebas PCR quincenales y a un test mensual para analizar su nivel de anticuerpo.

Los resultados arrojaron que, de los 6.614 sanitarios que tenían anticuerpos, solo 44 desarrollaron una “potencial” infección. Además, el estudio concluyó que la infección proporciona un 94 % de protección frente a la reinfección sintomática y un 75 % de inmunidad contra la reinfección asintomática.
En la investigación que estuvo dirigida por Susan Hopkins, los expertos apuntan a que los casos de reinfección detectados en el estudio, se consideran “potenciales” a la espera de un análisis genético que certifique la información.

No obstante, aclararon que aún no está confirmado que los resultados se puedan extrapolar a un grupo de población de mayor edad, teniendo en cuenta que quienes participaron en la investigación, su edad oscilaba entre 35 y 54 años, por lo que no descartan que puedan tener sistemas inmunes más robustos.
Por último, se anunció que la investigación se alargará durante doce meses, con el objetivo de establecer con exactitud la duración de la anhelada inmunidad. A su vez, durante ese período analizarán el impacto de la nueva cepa del coronavirus hallada en Reino Unido y también monitorearán la protección de los participantes que ya han recibido la vacuna.

A propósito, Reino Unido junto a Estados Unidos atravesaron su peor día de la pandemia, en momentos en que los países de todo el mundo endurecieron el miércoles las restricciones contra el virus y se pusieron en marcha campañas de vacunación masiva.
La Organización Mundial de la Salud dijo que hasta ahora se habían administrado 28 millones de dosis en todo el mundo, la mayoría en países ricos, y las autoridades sanitarias de los Estados Unidos dijeron que más de 10 millones de estadounidenses ya habían recibido sus primeras vacunas.
Los contagios mundiales se dispararon hasta superar los 91 millones y las muertes se acercaron a la marca de 2 millones, lo que obligó a los gobiernos de todo el mundo a reimponer nuevas restricciones, como confinamientos impopulares y dolorosos para la economía.
